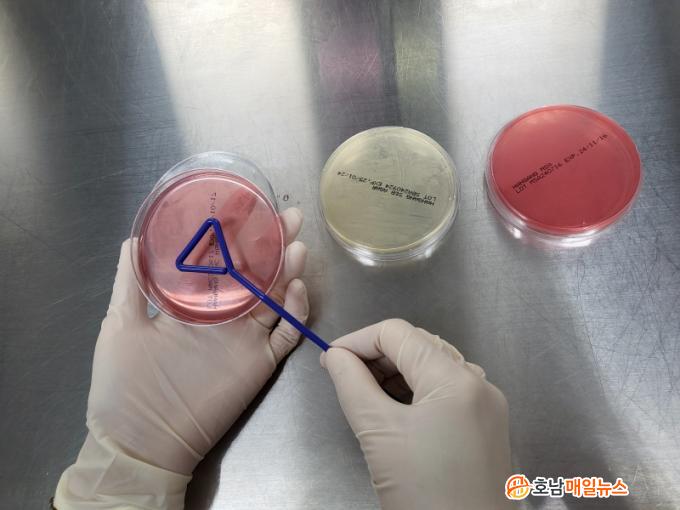

|
Á¥¼Ò Áúº´ Áß À¯¹æ¿°Àº ¼¼±Õ, °õÆÎÀÌ µî ¹Ì»ý¹°ÀÌ À¯¹æ¿¡ ħÀÔÇØ ¿°ÁõÀ» ÀÏÀ¸Å°´Â Áúº´ÀÌ´Ù. À¯¹æ¿°¿¡ °É¸° Á¥¼Ò´Â ¿øÀ¯ »ý»ê·®ÀÌ ÁÙ°í ¿øÀ¯¿¡ µé¾îÀÖ´Â ¼¼±Õ°ú ü¼¼Æ÷ ¼ö°¡ ´Ã¾î ¿ìÀ¯ÀÇ ÁúÀÌ ¶³¾îÁø´Ù. ¶ÇÇÑ ´Ù¸¥ Á¥¼Ò·ÎÀÇ °¨¿°, µµÅÂÀ² Áõ°¡, Ä¡·áºñ¿ë Áõ°¡ µî ³«³ó°¡¿¡ ¸·´ëÇÑ ¼Õ½ÇÀ» ÀÔÈù´Ù.
À¯¹æ¿°ÀÇ ÁÖ¿ä ¿øÀαÕÀº Æ÷µµ¾Ë±Õ¼Ó, Ȳ»öÆ÷µµ¾Ë±Õ, ´ëÀå±Õ µîÀÌ ÀÖ´Ù. Ãֱ٠ȯ°æ¼º¿¬¼â¾Ë±Õ, Àå¾Ë±Õ, Àå³» ¼¼±Õ µî ÁÖ·Î Ãà»ç ³» ±ò¤, ºÐº¯, Åä¾ç¿¡ ¼½ÄÇϴ ȯ°æ¼º ¼¼±Õ¿¡ ÀÇÇÑ À¯¹æ¿°ÀÌ ÀæÀº Ãß¼¼´Ù.
Àü³²µµµ¿¹°À§»ý½ÃÇè¼Ò´Â Áö¿ª¿¡¼ »ý»êµÈ ¿øÀ¯ÀÇ ¼¼±Õ¼ö, ü¼¼Æ÷¼ö µî À§»ýµî±Þ °Ë»ç¸¦ ¸ÅÁÖ ½Ç½ÃÇϰí, Á¥¼Ò À¯¹æ¿° ¿øÀÎ±Õ Áø´Ü ¹× Ç×»ýÁ¦ °¨¼ö¼º °Ë»ç¸¦ ÅëÇØ ³ó°¡¿¡ È¿°úÀû Ä¡·áÁ¦ Á¤º¸¸¦ Á¦°øÇÑ´Ù. ¶Ç À¯¹æ¿° µî Áúº´ ¿¹¹æÀ» À§ÇÑ Ãà»ç ȯ°æ °³¼± ¹× ¼Òµ¶, ÂøÀ¯ À§»ý°ü¸® Áöµµ¸¦ °ÈÇØ °íǰÁú ¿øÀ¯ »ý»ê¿¡ ÁÖ·ÂÇϰí ÀÖ´Ù.
Á¤Áö¿µ Àü³²µµµ¿¹°À§»ý½ÃÇè¼ÒÀåÀº ¡°Àϱ³Â÷°¡ Å« ȯÀý±â¿£ Áúº´¿¡ ³ëÃâµÇ±â ½¬¿ö ³ó°¡¿¡¼ ¼¼½ÉÇÑ °ü¸®°¡ ÇÊ¿äÇÏ´Ù¡±¸ç ¡°Ã¶ÀúÇÑ ¿øÀ¯ °Ë»ç¿Í ³«³ó°¡ Áúº´¡¤À§»ý°ü¸®¸¦ Áö¼ÓÀûÀ¸·Î ½Ç½ÃÇØ ³ó°¡ÀÇ °æÁ¦Àû ¼Õ½ÇÀ» ÃÖ¼ÒÈÇÏ°í ¾ÈÀüÇϰí Áú ÁÁÀº ¿ìÀ¯°¡ °ø±ÞµÇµµ·Ï Çϰڴ١±°í ¸»Çß´Ù.
ÃÖ±Ù Àü³²Áö¿ª 389°³ Á¥¼Ò ³ó°¡¿¡¼ »ý»êµÈ ¿øÀ¯´Â ¼¼±Õ¼ö 1µî±ÞÀÌ 99%ÀÌ»ó, ü¼¼Æ÷¼ö 1µî±ÞÀº Àü³âº¸´Ù 5% Áõ°¡ÇÑ 64%¸¦ ±â·ÏÇϰí ÀÖ´Ù.
2026.01.16 (±Ý) 16:39